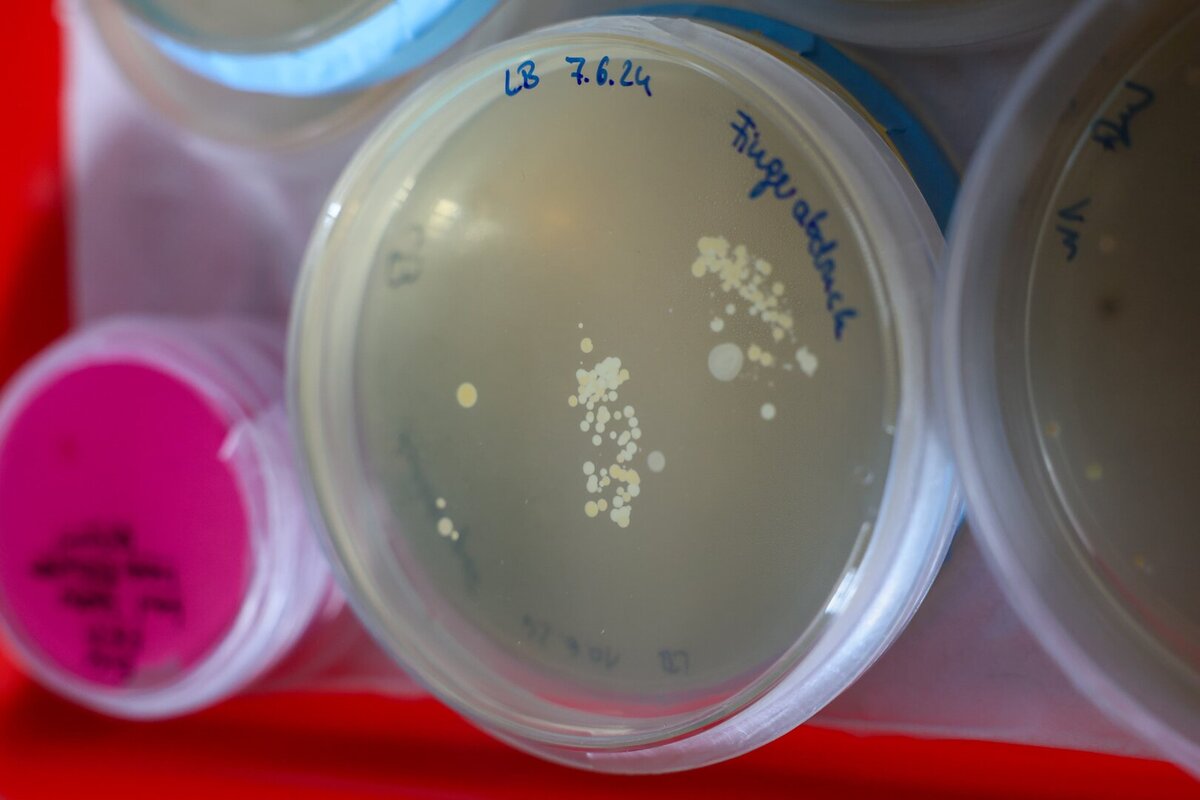

Wie ist es möglich, dass Parfüm Emotionen weckt, welche chemischen Prozesse laufen ab, wenn wir Schokolade essen, warum Kunststoffe Fluch und Segen zugleich sind und ob es der modernen Biotechnologie gelingt, künftig Milch oder Milchprodukte mittels Mikroben herzustellen? Das waren die Themen der Schauvorlesungen "Chemie im Alltag".
23. April 2024: Parfüm
14. Mai 2024: Schokolade
4. Juni 2024: Kunststoffe
11. Juni 2024: Mikroben